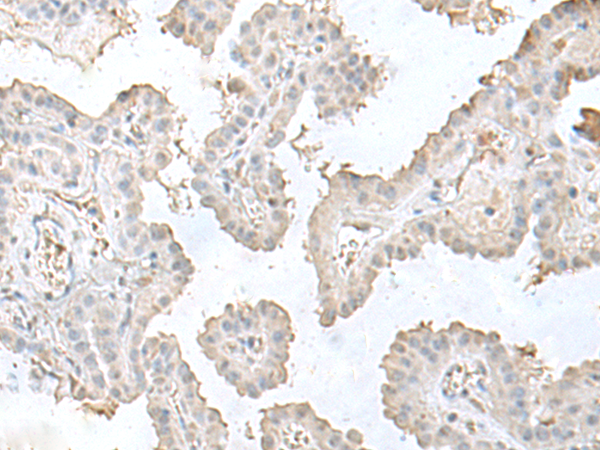
一抗

|
Background: |
LSm10 (U7 snRNA-associated Sm-like protein LSm10) is a nuclear protein that belongs to the snRNP (small nuclear ribonucleoproteins) Sm protein family. The survival of motor neurons (SMN) complex mediates the assembly of snRNPs involved in splicing and histone RNA processing. A crucial step in this process is the binding of Sm proteins onto the SMN protein. LSm10 and LSm11, mammalian homologs of the yeast Sm proteins D1 and D2, are important for U7 snRNP function and subcellular localization. U7 snRNP is an RNA molecule involved in the splicing of animal histone pre-mRNAs. Lsm10 and Lsm11 also associate with pICln (Chloride ion current inducer protein), which interacts with Sm proteins to inhibit their assembly on U RNA. LSm10 interactions with U7 snRNA and pICln may provide the means for using modified U7 snRNA derivatives to alter specific pre-mRNA splicing events, potentially leading to advances in antisense gene therapy. |
|
Applications: |
ELISA, IHC |
|
Name of antibody: |
LSM10 |
|
Immunogen: |
Fusion protein of human LSM10 |
|
Full name: |
LSM10, U7 small nuclear RNA associated |
|
Synonyms: |
MST074; MSTP074 |
|
SwissProt: |
Q969L4 |
|
ELISA Recommended dilution: |
5000-10000 |
|
IHC positive control: |
Human esophagus cancer |
|
IHC Recommend dilution: |
50-300 |

 購物車
購物車 幫助
幫助
 021-54845833/15800441009
021-54845833/15800441009